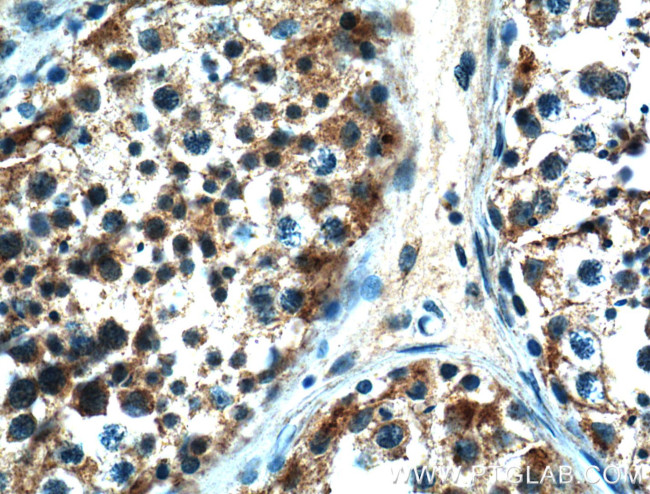
NOX5 Antibody in Immunohistochemistry (Paraffin) (IHC (P))

Search
Proteintech
NOX5 Polyclonal Antibody
{{$productOrderCtrl.translations['antibody.pdp.commerceCard.promotion.promotions']}}
{{$productOrderCtrl.translations['antibody.pdp.commerceCard.promotion.viewpromo']}}
{{$productOrderCtrl.translations['antibody.pdp.commerceCard.promotion.promocode']}}: {{promo.promoCode}} {{promo.promoTitle}} {{promo.promoDescription}}. {{$productOrderCtrl.translations['antibody.pdp.commerceCard.promotion.learnmore']}}
产品信息
25350-1-AP
种属反应
宿主/亚型
分类
类型
抗原
偶联物
形式
浓度
规格
纯化类型
保存液
内含物
保存条件
运输条件
产品详细信息
Immunogen sequence: YRHQKRKHT CPSCQHSWIE GVQDNMKLHK VDFIWINRDQ RSFEWFVSLL TKLEMDQAEE AQYGRFLELH MYMTSALGKN DMKAIGLQMA LDLLANKEKK DSITGLQTRT QPGRPDWSKV FQKVAAEKKG KVQVFFCGSP ALAKVLKGHC EKFGFRFFQE NF (605-765 aa encoded by BC125098)
靶标信息
This gene is predominantly expressed in the testis and lymphocyte-rich areas of spleen and lymph nodes. It encodes a calcium-dependen NADPH oxidase that generates superoxide, and functions as a calcium-dependent proton channel that may regulate redox-dependent processes in lymphocytes and spermatozoa. Alternatively spliced transcript variants encoding different isoforms have been described for this gene. [provided by RefSeq, Oct 2011].
仅用于科研。不用于诊断过程。未经明确授权不得转售。
生物信息学
蛋白别名: NADPH oxidase 5; NADPH oxidase, EF-hand calcium binding domain 5; NOX5 alpha; NOX5 gamma; NOX5S; NOX5zeta; unnamed protein product
基因别名: NOX5
UniProt ID: (Human) Q96PH1
Entrez Gene ID: (Human) 79400